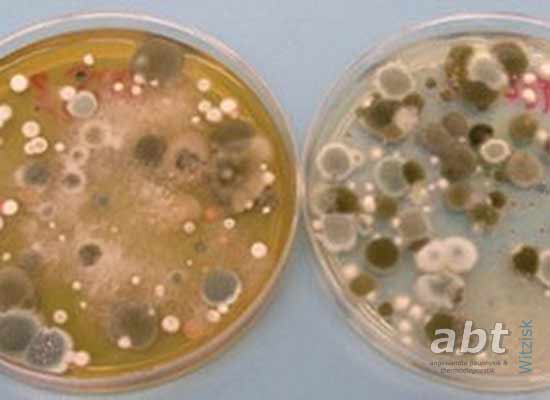

Messungen & Analysen Luftkeimen, Pilzsporen
Luftkeim-Messung
Um die in der Luft befindlichen Schimmelpilzsporen zu messen und zu bewerten, werden sie mit einem Luftkeimsammler auf spezielle Nährböden aufgebracht und angezüchtet.
Der Luftkeimsammler nimmt gerade nur so viel Luft auf, so dass die Kolonien auf einem Nährmedium gut auszählbar sind. Die Angabe der Ergebnisse einer Luftkeimsammlung erfolgt als "koloniebildende Einheiten" (KBE) pro Kubikmeter Luft.
Welche Vorteile hat die Luftkeimsammlung?
- Wachstum und mikroskopische Auszählung von sichtbaren Kolonien
- Schimmelpilze können hinsichtlich ihrer Art identifiziert werden.
- im Gegensatz zur mikroskopischen Auswertung machen sich Störfaktoren wie z.B. hoher Partikelgehalt nicht bemerkbar.